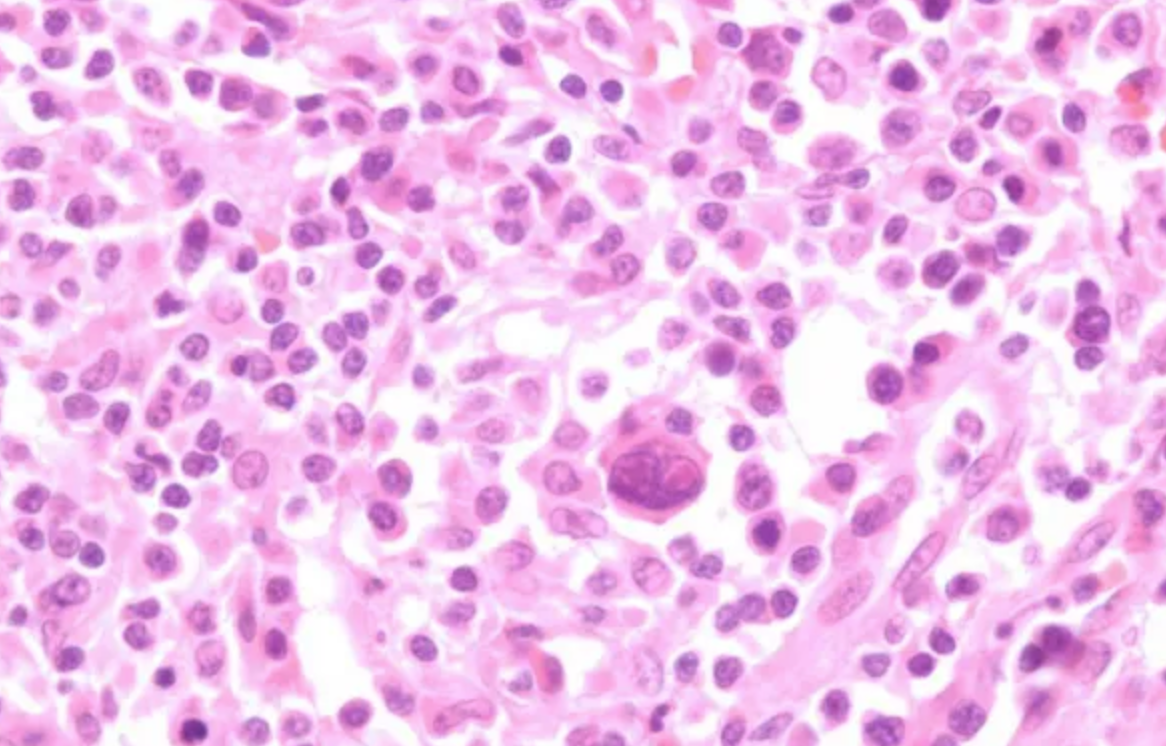

악성 림프종 (lymphoma)
악성 림프종 개요
정의 및 특징
림프계의 악성 종양: 면역체계를 구성하는 림프구가 비정상적으로 과다 증식하여 형성
단클론성 증식: 하나의 비정상적인 세포에서 기원하여 무한 증식
주요 발생 위치: 림프절, 비장, 편도, 골수 등 림프 조직 어디에서나 발생 가능
소아청소년 3번째로 흔한 악성 종양 (1위: 백혈병, 2위: 중추신경계 종양)
주요 분류: 병리조직학적 소견에 따라 크게 두 가지로 분류
호지킨 림프종 (Hodgkin Lymphoma, HL)
비호지킨 림프종 (Non-Hodgkin Lymphoma, NHL)
임상양상
림프절 종대
통증 없고 단단하며, 고무 같은 질감
흔한 부위: 목(경부), 쇄골 위(쇄골상부), 겨드랑이(액와부)
B 증상 (B symptoms): 전신 증상으로 예후와 관련
발열: 38℃ 이상의 원인 불명 발열
체중 감소: 지난 6개월간 10% 이상 의미 있는 감소
야간 발한: 잠옷이나 침구를 흠뻑 적실 정도의 심한 땀
종괴 효과 (Mass Effect)
종격동(가슴) 침범 시: 기침, 흉통, 호흡곤란, 상대정맥 증후군
복부 침범 시: 복통, 복부 팽만, 장중첩증 (특히 NHL)
진단 및 병기 설정
확진
조직 생검: 필수적이며 가장 중요한 검사
→ 림프절 절제 생검(Excisional biopsy)을 원칙으로 함
병기 설정을 위한 검사
병력 청취 및 신체검사: B 증상 유무, 림프절 및 장기 크기 확인
혈액 검사: CBC, ESR, LDH, 간/신장 기능 검사
영상 검사: 흉부 X-ray, CT (목, 흉부, 복부, 골반), PET-CT (필수)
골수 검사 (Bone Marrow Biopsy): 골수 침범 여부 확인 (stage III+ or B symptom)
병기 (Ann Arbor Staging System)
Stage I: 1개의 림프절 구역 침범
Stage II: 횡격막을 기준으로 한쪽에 2개 이상의 림프절 구역 침범
Stage III: 횡격막을 기준으로 양쪽에 모두 림프절 구역 침범
Stage IV: 림프절 외 장기(간, 폐, 골수 등)에 파종성으로 침범
수식어:
A: B 증상 없음
B: B 증상 있음
E: 림프절 외 장기를 국소적으로 침범 (Extranodal)
호지킨 림프종 (Hodgkin Lymphoma)
역학: two-peak (15-35세 및 50세 이상)
WHO 분류
고전적 호지킨 림프종 (결절성 경화, 혼합 세포, 림프구 풍부, 림프구 고갈): RS cell 확인
결절성 림프구 우세형 (RS cell이 잘 보이지 않고 popcorn cell이 특징적으로 보임
병리소견
Reed-Sternberg cell: 특징적인 모양의 거대 종양 세포
배경에 다양한 염증 세포 침윤
치료
저위험군 (stage I, IIA): 항암치료(ABVD or OEPA) (± 국소 방사선치료, 반응 적을시)
중등도위험군(B 증상, bulky disease, mediastinal mass, E+): 항암치료 (ABVE-PC) (± 국소 RT)
진행 병기 (stage III, IV): 항암치료(ABVE-PC or nivolumab-AVD) ± 방사선치료
비호지킨 림프종 (Non-Hodgkin Lymphoma, NHL)
특징 및 역학
소아 림프종의 60% 차지 (호지킨 림프종보다 흔함)
리드-슈테른베르크 세포 없음
빠른 진행: 대부분 고등급(high-grade), 공격적인 경과
림프절 외 침범: 골수, 중추신경계, 복부 장기 등 초기부터 흔하게 발생
호발 연령: 15세 미만 소아에서 주로 발생, 연령에 따라 아형 분포 다름
주요 병리조직학적 아형: 소아 NHL은 성인과 달리 특정 아형이 대부분을 차지
버킷 림프종 (Burkitt Lymphoma): m/c, 약 40%
B세포 기원, EBV감염과 연관
매우 빠른 증식 속도 (종양 doubling time < 24시간)
복부 종괴: 특히 회맹부(ileocecal)에 호발하여 복통, 장폐쇄, 장중첩증 유발
턱(jaw) 침범은 아프리카 풍토병 지역에서 특징적
림프모구성 림프종 (Lymphoblastic Lymphoma): 2nd m/c, 약 30%
T세포 기원이 대부분
종격동 종괴: 흉선(thymus)에서 기원하여 기침, 호흡곤란, 상대정맥 증후군 유발
급성 림프모구성 백혈병(ALL)과 생물학적으로 유사
미만성 거대 B세포 림프종 (Diffuse Large B-cell Lymphoma, DLBCL): (약 15%)
B세포 기원
다양한 부위(림프절, 위장관, 뼈 등) 침범
역형성 대세포 림프종 (Anaplastic Large Cell Lymphoma, ALCL): (약 10%)
T세포 기원
피부, 림프절, 뼈, 연조직 등 침범
ALK (Anaplastic Lymphoma Kinase) 유전자 재배열이 특징적
임상양상
발병 부위에 따라 매우 다양
복부 증상 (버킷 림프종): 복통, 복부팽만, 오심/구토, 장중첩증, 복수
흉부 증상 (림프모구성 림프종): 기침, 흉통, 호흡곤란, 상대정맥 증후군 (얼굴과 상지 부종)
림프절 종대: 목, 겨드랑이, 서혜부 등
중추신경계 침범: 두통, 구토, 뇌신경 마비
종양 용해 증후군 (Tumor Lysis Syndrome, TLS)
종양이 급격히 파괴되면서 발생. 특히 버킷 림프종에서 호발
고칼륨혈증, 고인산혈증, 고요산혈증, 저칼슘혈증
급성 신부전, 부정맥 등 유발 가능. 응급 상황
치료
기본 원칙: 단기간의 강력한 복합 항암화학요법
아형 및 병기에 따른 치료
B세포 림프종 (버킷, DLBCL): R-CHOP 등
T세포 림프종 (림프모구성): 급성 림프모구성 백혈병(ALL)에 준한 치료
역형성 대세포 림프종: ALCL99 요법
중추신경계 예방: 뇌척수강 내 항암제 주입 및 고용량 전신 항암제 투여
종양 용해 증후군 예방/치료: 수액 공급, 알칼리화, 알로푸리놀(Allopurinol) 또는 라스부리케이즈(Rasburicase) 투여
연습문제 13문제
0/13 완료
0개의 글
** 제목만 보더라도 어떤 내용인지 알 수 있도록 완성된 문장으로 작성해주세요.
예시) 초음파 (X) → 초음파 사진에서 PDA 소견을 어떻게 알 수 있나요? (O)